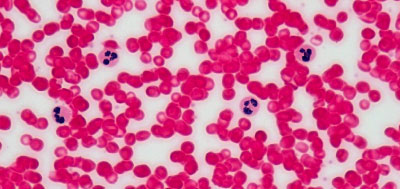

Hematologo en campeche
Es una rama de la medicina dedicada al análisis de la sangre y sus alteraciones. Los hematólogos son profesionales especializados en el estudio de la sangre y de sus componentes, como las células sanguíneas y las que se producen en la médula ósea.

Neoplasias hematológicas
Son aquellos cánceres que se originan en el tejido hematopoyético. Con frecuencia se forman en la médula ósea.

Trombosis
Es una afección que ocurre cuando se forma un coágulo de sangre en una vena profunda.

Anemia
Se desarrolla cuando la sangre produce una cantidad inferior a la normal de glóbulos rojos sanos.
Neutropenia
Son aquellos cánceres que se originan en el tejido hematopoyético. Con frecuencia se forman en la médula ósea.

Trombocitopenia
Es una afección que ocurre cuando se forma un coágulo de sangre en una vena profunda.

Enfermedades Hemorrágicas
Se desarrolla cuando la sangre produce una cantidad inferior a la normal de glóbulos rojos sanos.
¿Cuándo acudir al hematólogo?
Palidez y cansancio suelen ser síntomas de enfermedades en los glóbulos rojos.
Fiebre, picor e hinchazón de los ganglios linfáticos y del bazo. (Enfermedades de los glóbulos blancos).

Formación de trombos y coágulos o aparición de manchas cutáneas (enfermedades plaquetarias).